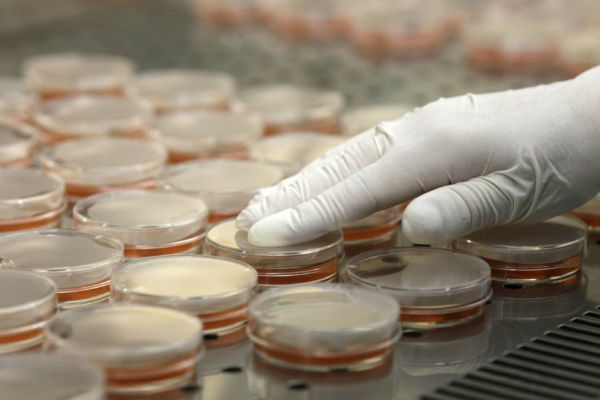

Prvi koji bi mogao uvesti ovaj porez je Kanton Sarajevo (KS). Premijer KS, Nihad Uk, potvrdio je za Forbes BiH da je Vlada angažovala eksterne stručnjake zajedno s partnerima iz UNDP-a kako bi pronašli zakonsko rješenje koje bi imalo višestruku korist za zajednicu.
„Na jednoj od sjednica proteklog mjeseca imali smo kratku prezentaciju o aktivnostima koje smo do sada uradili. Ocijenili smo da veliki broj nekretnina u KS stoji prazno, da imamo balon cijena koje nisu realne, te nam je cilj da u tom segmentu uredimo tržište, da ‘otključamo’ te nekretnine, spustimo malo njihovu cijenu, ali i da motiviramo i angažujemo vlasnike stanova i poslovnih prostora da ih stave u promet kroz rentanje. Veći broj stanova i poslovnih prostora na tržištu doveo bi do pada cijena najma,“ rekao je Uk.
U BiH nema preciznih podataka o broju praznih nekretnina, ali ranija istraživanja su pokazala da ih je oko 60.000. Nedostatak centralizovanog popisa otežava donošenje tačnih zaključaka, pišu nezavisne.